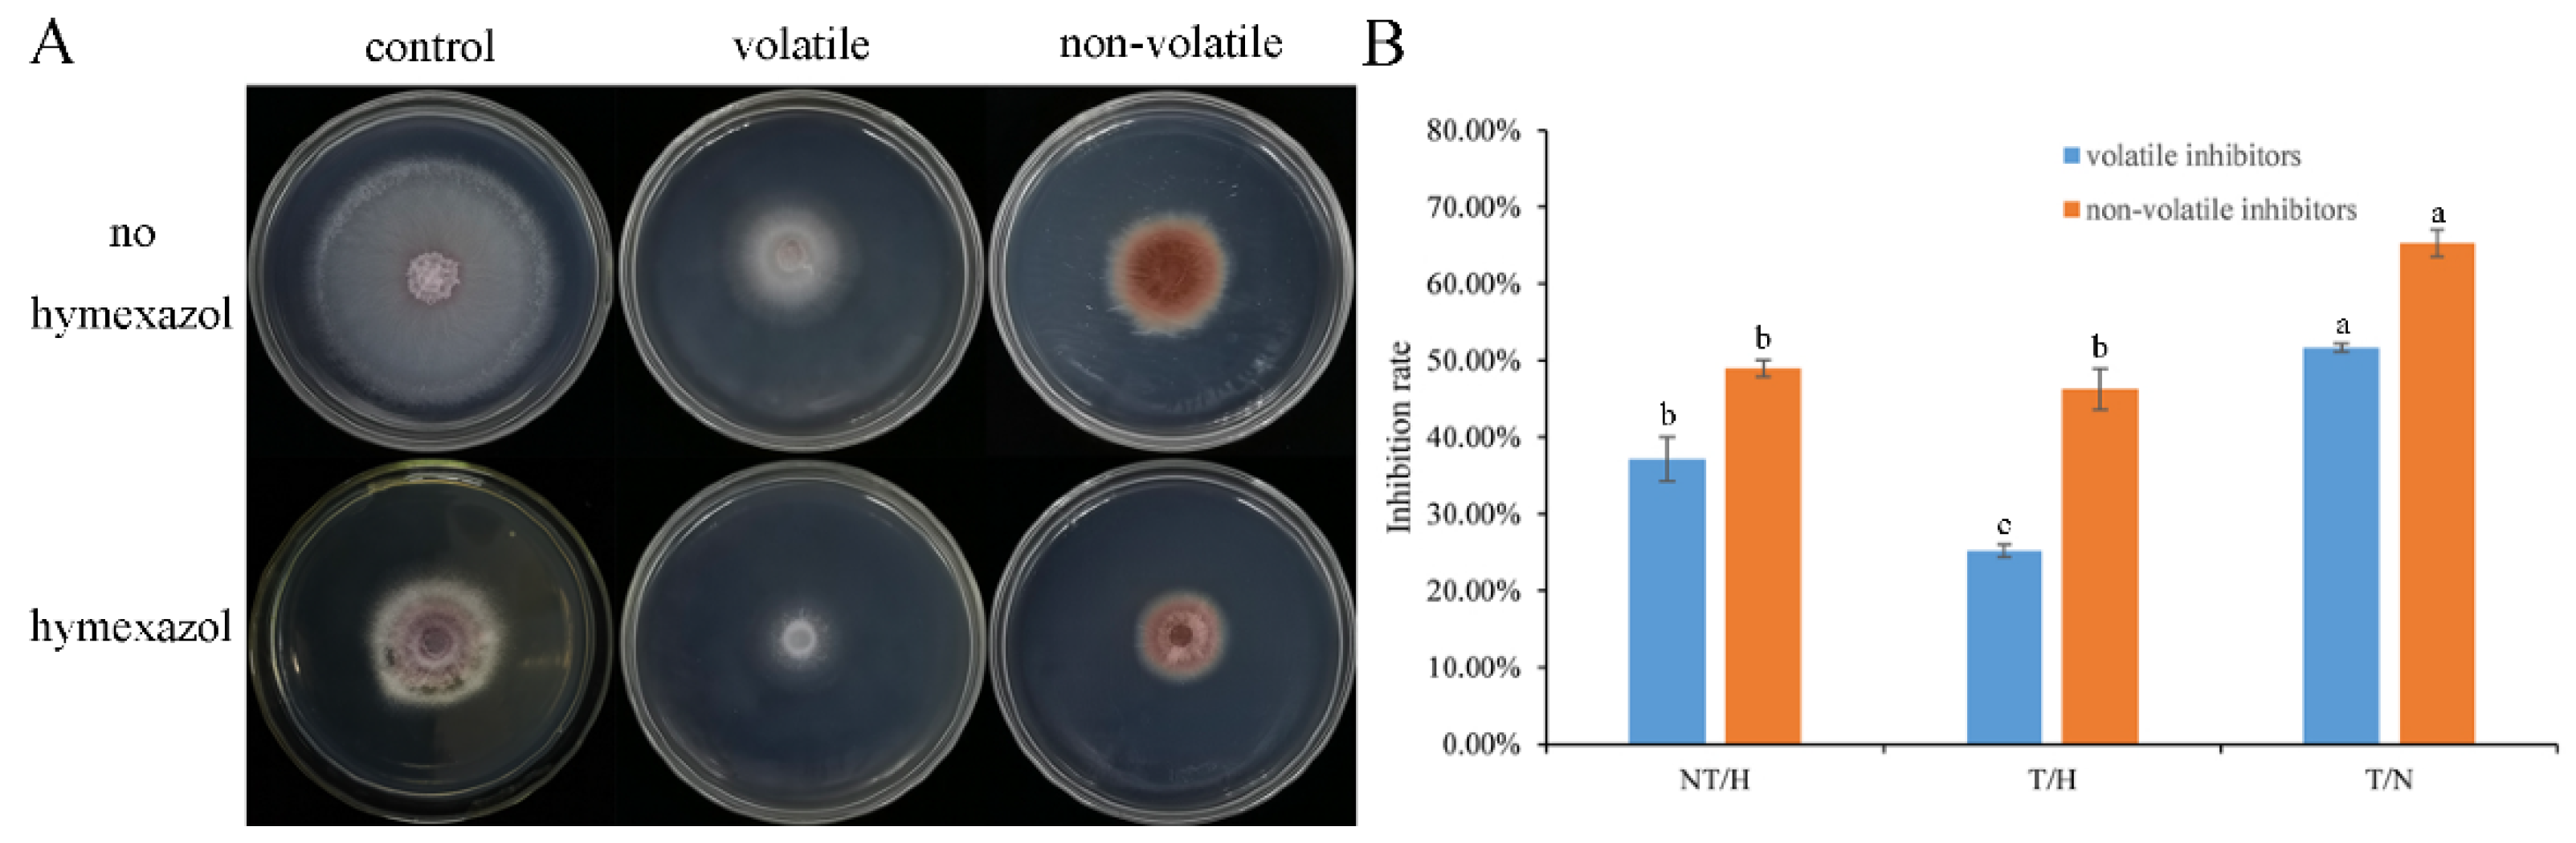

The Combination of a Biocontrol Agent Trichoderma asperellum SC012 and Hymexazol Reduces the Effective Fungicide Dose to Control Fusarium Wilt in Cowpea
Abstract
:1. Introduction
2. Materials and Methods
2.1. Fungal Isolates and Pesticide
2.2. Sensitivity Test of Trichoderma Strains and F. oxysporum to Hymexazol
2.3. Taxonomic Classification of Hymexazol-Tolerant Trichoderma
2.4. The Antagonistic Effect of the Combination of Hymexazol-Tolerant Trichoderma and Hymexazol to F. oxysporum
2.5. Analysis for Antagonistic Activity between Trichoderma and F. oxysporum
2.5.1. Trypan Blue Staining
2.5.2. Effect of Volatile and Non-Volatile Metabolites Produced by Trichoderma SC012 Strain
2.6. Trichoderma Population Dynamics in Rhizosphere Soil of Cowpea
2.7. Greenhouse Experiments
2.8. Field Experiments
2.9. Statistical Analyses
3. Results
3.1. The Sensitivity of Trichoderma SC012 Strain and F. oxysporum FC018 to Hymexazol
3.2. Taxonomic Classification of Trichoderma SC012 Strain
3.3. Antagonism of the Combination of Trichoderma and Hymexazol to F. oxysporum
3.4. Colonization of Trichoderma SC012 Strain in the Rhizosphere Soil of Cowpea
3.5. The Combination of Trichoderma and Hymexazol Can Effectively Control Cowpea Fusarium Wilt in Greenhouse
3.6. The Combination of Trichoderma and Hymexazol Can Effectively Control Cowpea Fusarium Wilt in Field
4. Discussion
Author Contributions
Funding
Institutional Review Board Statement
Informed Consent Statement
Data Availability Statement
Conflicts of Interest
References
- Singh, S.; Nag, S.K.; Kundu, S.S.; Maity, S.B. Relative intake, eating pattern, nutrient digestibility, nitrogen metabolism, fermentation pattern and growth performance of lambs fed organically and inorganically produced cowpea hay-barley grain diets. Trop. Grassl. 2010, 44, 55–61. [Google Scholar] [CrossRef]
- Reddy, L.J.; Upadhyaya, H.D.; Gowda, C.; Singh, S. Development of Core Collection in Pigeonpea [Cajanus cajan (L.) Millspaugh] using Geographic and Qualitative Morphological Descriptors. Genet. Resour. Crop Evol. 2005, 52, 1049–1056. [Google Scholar] [CrossRef]
- Singh, B.B. Cowpea [Vigna unguiculata (L.)] Walp. In Genetic Resources, Chromosome Engineering and Crop Improvemen; Singh, R.J., Jauhar, P.P., Eds.; CRC Press: Boca Raton, FL, USA, 2005; Volume 1, pp. 117–162. [Google Scholar] [CrossRef]
- Reddy, M.V.; Sharma, S.B.; Nene, Y.L. Pigeonpea: Disease management. In The Pigeonpea; Nene, Y.L., Hall, S.D., Sheila, V.K., Eds.; CAB International: Wallingford, UK, 1990; pp. 303–347. [Google Scholar]
- Beckman, C.H. The Nature of Wilt Diseases of Plants; APS Press: St. Paul, MN, USA, 1987; p. 176. [Google Scholar]
- Nelson, P.E. Life Cycle and Epidemiology of Fusarium oxysporum—ScienceDirect. Fungal Wilt Dis. Plants 1981, 51–80. [Google Scholar] [CrossRef]
- Rowe, R.C. Strategies for Controlling Fusarium Crown and Root Rot in Greenhouse Tomatoes. Plant Dis. 1981, 65, 107. [Google Scholar] [CrossRef]
- Kumar, K.; Amaresan, N.; Bhagat, S.; Madhuri, K.; Srivastava, R.C. Isolation and Characterization of Trichoderma spp. for Antagonistic Activity Against Root Rot and Foliar Pathogens. Indian J. Microbiol. 2012, 52, 137–144. [Google Scholar] [CrossRef] [Green Version]
- Castillo, A.G.; Puig, C.G.; Cumagun, C.J.R. Non-Synergistic Effect of Trichoderma harzianum and Glomus spp. in Reducing Infection of Fusarium Wilt in Banana. Pathogens 2019, 8, 43. [Google Scholar] [CrossRef] [PubMed] [Green Version]
- Hewedy, O.A.; Abdel-lateif, K.S.; Bakr, R.A. Genetic diversity and biocontrol efficacy of indigenous Trichoderma isolates against Fusarium wilt of pepper. J. Basic Microb. 2019, 60, 126–135. [Google Scholar] [CrossRef] [PubMed]
- Yang, X.M.; Chen, L.H.; Yong, X.Y.; Shen, Q.R. Formulations can affect rhizosphere colonization and biocontrol efficiency of Trichoderma harzianum SQR-T037 against Fusarium wilt of cucumbers. Biol. Fert. Soils 2011, 47, 239–248. [Google Scholar] [CrossRef]
- Zhang, Y.; Tian, C.; Xiao, J.L.; Wei, L.; Tian, Y.; Liang, Z.H. Soil inoculation of Trichoderma asperellum M45a regulates rhizosphere microbes and triggers watermelon resistance to Fusarium wilt. AMB Express 2020, 10, 1–13. [Google Scholar] [CrossRef] [PubMed]
- Harman, G.E. Overview of Mechanisms and Uses of Trichoderma spp. Phytopathology 2006, 96, 190–194. [Google Scholar] [CrossRef] [PubMed] [Green Version]
- Mukherjee, M.; Mukherjee, P.K.; Horwitz, B.A.; Zachow, C.; Berg, G.; Zeilinger, S. Trichoderma-Plant-Pathogen Interactions: Advances in Genetics of Biological Control. Indian J. Microbiol. 2012, 52, 522–529. [Google Scholar] [CrossRef] [Green Version]
- Stracquadanio, C.; Quiles, J.M.; Meca, G.; Cacciola, S.O. Antifungal Activity of Bioactive Metabolites Produced by Trichoderma asperellum and Trichoderma atroviride in Liquid Medium. J. Fungi 2020, 6, 263. [Google Scholar] [CrossRef] [PubMed]
- Stracquadanio, C.; Luz, C.; La Spada, F.; Meca, G.; Cacciola, S.O. Inhibition of Mycotoxigenic Fungi in Different Vegetable Matrices by Extracts of Trichoderma Species. J. Fungi 2021, 7, 445. [Google Scholar] [CrossRef] [PubMed]
- Lorito, M.; Woo, S.L.; Harman, G.E.; Monte, E. Translational Research on Trichoderma: From ‘Omics to the Field. Annu. Rev. Phytopathol. 2010, 48, 395–417. [Google Scholar] [CrossRef] [PubMed] [Green Version]
- Harman, G.E.; Howell, C.R.; Viterbo, A.; Chet, I.; Lorito, M. Trichoderma species—Opportunistic, avirulent plant symbionts. Nat. Rev. Microbiol. 2004, 2, 43–56. [Google Scholar] [CrossRef]
- Tomah, A.A.; Abd Alamer, I.S.; Li, B.; Zhang, J.Z. A new species of Trichoderma and gliotoxin role: A new observation in enhancing biocontrol potential of T. virens against Phytophthora capsici on chili pepper. Biol. Control 2020, 145, 104261. [Google Scholar] [CrossRef]
- Getha, K.; Vikineswary, S.; Wong, W.H.; Seki, T.; Ward, A.; Goodfellow, M. Evaluation of Streptomyces sp. strain g10 for suppression of Fusarium wilt and rhizosphere colonization in pot-grown banana plantlets. J. Ind. Microbiol. Biotechnol. 2005, 32, 24–32. [Google Scholar] [CrossRef]
- Abo-Elyousr, K.A.M.; Hashem, M.; Ali, E.H. Integrated control of cotton root rot disease by mixing fungal biocontrol agents and resistance inducers. Crop Prot. 2009, 28, 295–301. [Google Scholar] [CrossRef]
- Myresiotis, C.K.; Karaoglanidis, G.S.; Vryzas, Z.; Papadopoulou-Mourkidou, E. Evaluation of plant-growth-promoting rhizobacteria, acibenzolar-S-methyl and hymexazol for integrated control of Fusarium crown and root rot on tomato. Pest Manag. Sci. 2012, 68, 404–411. [Google Scholar] [CrossRef]
- Obradovic, A.; Jones, J.B.; Momol, M.T.; Olson, S.M.; Jackson, L.E.; Balogh, B.; Guven, K.; Iriarte, F.B. Integration of Biological Control Agents and Systemic Acquired Resistance Inducers Against Bacterial Spot on Tomato. Plant Dis. 2005, 89, 712–716. [Google Scholar] [CrossRef] [Green Version]
- Roberts, T.R.; Hutson, D.H. Metabolic pathways of agrochemicals. Part 2: Insecticides and fungicides. R. Soc. Chem. 1999. [Google Scholar] [CrossRef]
- Fan, Y.; Gao, R.H.; Xiao, X.; Tao, Z. Inclusion Complexes of Hymexazol with Three Different Cucurbit[n]uril: Preparation, and Physicochemical and Antifungal Characterization. Israel J. Chem. 2018, 58, 466–471. [Google Scholar] [CrossRef]
- Lu, H.; Zou, W.X.; Meng, J.C.; Hu, J.; Tan, R.X. New bioactive metabolites produced by Colletotrichum sp., an endophytic fungus in Artemisia annua. Plant Sci. 2000, 151, 67–73. [Google Scholar] [CrossRef]
- Stewart, C.N., Jr.; Via, L.E. A rapid CTAB DNA isolation technique useful for RAPD fingerprinting and other PCR applications. BioTechniques 1993, 14, 748–750. [Google Scholar] [PubMed]
- Druzhinina, I.S.; Kopchinskiy, A.G.; Komon, M.; Bissett, J.; Szakacs, G.; Kubicek, C.P. An oligonucleotide barcode for species identification in Trichoderma and Hypocrea. Fungal Genet. Biol. 2005, 42, 813–828. [Google Scholar] [CrossRef] [PubMed]
- Strober, W. Trypan Blue Exclusion Test of Cell Viability. Curr. Protoc. Immunol. 2015, 111, A3.B.1–A3.B.3. [Google Scholar] [CrossRef]
- Dennis, C.; Webster, J. Antagonistic properties of species-groups of Trichoderma: I. Production of non-volatile antibiotics. Trans. Br. Mycol. Soc. 1971, 57. [Google Scholar] [CrossRef]
- Dennis, C.; Webster, J. Antagonistic properties of species-groups of Trichoderma: II. Production of volatile antibiotics. Trans. Br. Mycol. Soc. 1971, 57, 1. [Google Scholar] [CrossRef]
- Marco, S. Gnotobiotic System for Studying Rhizosphere Colonization by Plant Growth-Promoting Pseudomonas Bacteria Gnotobiotic System for Studying Rhizosphere. Mol. Plant-Microbe Interact. 1996, 9, 600–607. [Google Scholar] [CrossRef]
- Pai, S.G.; Riley, M.B.; Camper, N.D. Microbial degradation of mefenoxam in rhizosphere of Zinnia angustifolia. Chemosphere 2001, 44, 577–582. [Google Scholar] [CrossRef]
- Rigert, K.S.; Foster, K.W. Inheritance of Resistance to Two Races of Fusarium Wilt in Three Cowpea Cultivars. Crop Sci. 1987, 27, 220–224. [Google Scholar] [CrossRef]
- Samuels, G.J.; Lieckfeldt, E.; Nirenberg, H.I. Trichoderma asperellum, a new species with waited conidia, and redescription of T. viride. Sydowia 1999, 51, 71–88. [Google Scholar] [CrossRef]
- Meyer, S.L.F.; Roberts, D.P. Combinations of biocontrol agents for management of plant-parasitic nematodes and soilborne plant-pathogenic fungi. J. Nematol. 2002, 34, 1–8. [Google Scholar] [PubMed]
- Raupach, G.S.; Kloepper, J.W. Mixtures of plant growth-promoting rhizobacteria enhance biological control of multiple cucumber pathogens. Phytopathology 1998, 88, 1158–1164. [Google Scholar] [CrossRef] [PubMed] [Green Version]
- Payne, P.A.; Williams, G.E. Hymexazol treatment of sugar-beet seed to control seedling disease caused by Pythium spp. and Aphanomyces cochlioides. Crop Prot. 1990, 9, 371–377. [Google Scholar] [CrossRef]
- Xu, H.; Jian, K.-Z.; Guan, Q.; Ye, F.; Lv, M. Antifungal activity of some diaryl ethers. Chem. Farm. Bull. 2007, 55, 1755–1757. [Google Scholar] [CrossRef] [Green Version]
- Wang, S.Q.; Ma, J.; Wang, M.; Wang, X.H.; Li, Y.Q.; Chen, J. Combined application of Trichoderma harzianum SH2303 and difenoconazole-propiconazolein controlling Southern corn leaf blight disease caused by Cochliobolus heterostrophus in maize. J. Integr. Agr. 2019, 18, 2063–2071. [Google Scholar] [CrossRef]
- El_Komy, M.H.; Saleh, A.A.; Ibrahim, Y.E.; Hamad, Y.K.; Molan, Y.Y. Trichoderma asperellum strains confer tomato protection and induce its defense-related genes against the Fusarium wilt pathogen. Trop. Plant Pathol. 2016, 41, 277–287. [Google Scholar] [CrossRef]
- Thangavelu, R.; Gopi, M. Combined application of native Trichoderma isolates possessing multiple functions for the control of Fusarium wilt disease in banana cv. Grand Naine. Biocontrol Sci. Technol. 2015, 25, 1147–1164. [Google Scholar] [CrossRef]
- Karlsson, M.; Atanasova, L.; Dan, F.J.; Zeilinger, S. Necrotrophic Mycoparasites and Their Genomes. Microbiol. Spectr. 2017, 5. [Google Scholar] [CrossRef]
- Kloepper, J.W.; Beauchamp, C.J. A review of issues related to measuring colonization of plant roots by bacteria. Can. J. Microbiol. 1992, 38, 1219–1232. [Google Scholar] [CrossRef]
- Jung, S.C.; Martinez-Medina, A.; Lopez-Raez, J.A.; Pozo, M.J. Mycorrhiza-Induced Resistance and Priming of Plant Defenses. J. Chem. Ecol. 2012, 38, 651–664. [Google Scholar] [CrossRef] [PubMed]
- La Spada, F.; Stracquadanio, C.; Riolo, M.; Pane, A.; Cacciola, S.O. Trichoderma Counteracts the Challenge of Phytophthora nicotianae Infections on Tomato by Modulating Plant Defense Mechanisms and the Expression of Crinkler, Necrosis-Inducing Phytophthora Protein 1, and Cellulose-Binding Elicitor Lectin Pathogenic Effectors. Front. Plant Sci. 2020, 11, 583539. [Google Scholar] [CrossRef]
- Benizri, E.; Baudoin, E.; Guckert, A. Root Colonization by Inoculated Plant Growth-Promoting Rhizobacteria. Biocontrol Sci. Technol. 2001, 11, 557–574. [Google Scholar] [CrossRef]

| Taxonomic Status | Strains | EC50 (µg mL−1) |
|---|---|---|
| Trichoderma | SC012 | 263.68 ± 4.01 a |
| LS007-21 | 192.02 ± 0.98 c | |
| HN082102.1 | 128.53 ± 3.16 d | |
| HL167 | 153.55 ± 3.51 e | |
| DQ1 | 226.01 ± 2.65 b | |
| F. oxysporum | FC018 | 62.15 ± 1.78 f |
Publisher’s Note: MDPI stays neutral with regard to jurisdictional claims in published maps and institutional affiliations. |
© 2021 by the authors. Licensee MDPI, Basel, Switzerland. This article is an open access article distributed under the terms and conditions of the Creative Commons Attribution (CC BY) license (https://creativecommons.org/licenses/by/4.0/).
Share and Cite
Zhang, C.; Wang, W.; Xue, M.; Liu, Z.; Zhang, Q.; Hou, J.; Xing, M.; Wang, R.; Liu, T. The Combination of a Biocontrol Agent Trichoderma asperellum SC012 and Hymexazol Reduces the Effective Fungicide Dose to Control Fusarium Wilt in Cowpea. J. Fungi 2021, 7, 685. https://doi.org/10.3390/jof7090685
Zhang C, Wang W, Xue M, Liu Z, Zhang Q, Hou J, Xing M, Wang R, Liu T. The Combination of a Biocontrol Agent Trichoderma asperellum SC012 and Hymexazol Reduces the Effective Fungicide Dose to Control Fusarium Wilt in Cowpea. Journal of Fungi. 2021; 7(9):685. https://doi.org/10.3390/jof7090685
Chicago/Turabian StyleZhang, Chongyuan, Weiwei Wang, Ming Xue, Zhen Liu, Qinman Zhang, Jumei Hou, Mengyu Xing, Rui Wang, and Tong Liu. 2021. "The Combination of a Biocontrol Agent Trichoderma asperellum SC012 and Hymexazol Reduces the Effective Fungicide Dose to Control Fusarium Wilt in Cowpea" Journal of Fungi 7, no. 9: 685. https://doi.org/10.3390/jof7090685
APA StyleZhang, C., Wang, W., Xue, M., Liu, Z., Zhang, Q., Hou, J., Xing, M., Wang, R., & Liu, T. (2021). The Combination of a Biocontrol Agent Trichoderma asperellum SC012 and Hymexazol Reduces the Effective Fungicide Dose to Control Fusarium Wilt in Cowpea. Journal of Fungi, 7(9), 685. https://doi.org/10.3390/jof7090685

